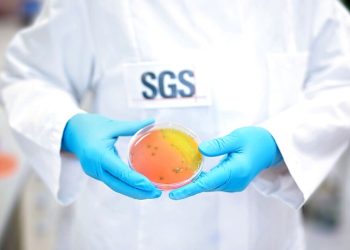
SGS to host webinar ‘Unlocking the Secrets of Food Safety: A Deep Dive into Microbiological Challenge Testing’

Expanded ISM Middle East to provide global perspective and connections to sweets and snacks sector
ISM Middle East 2024, the region's sole and most awaited sweets and snacks trade event, will be taking place in a larger event space than ever before this year. Meeting...
Read moreDetails